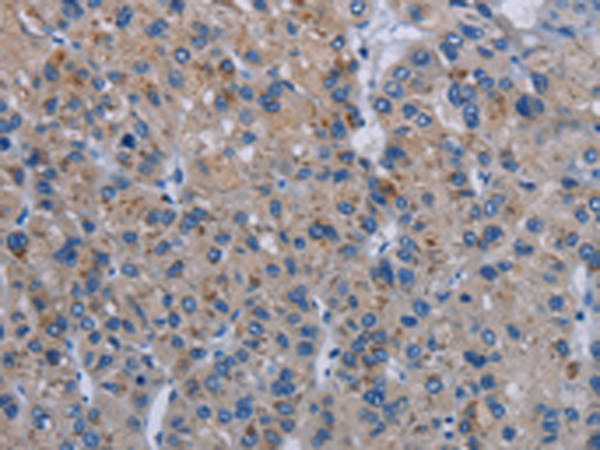
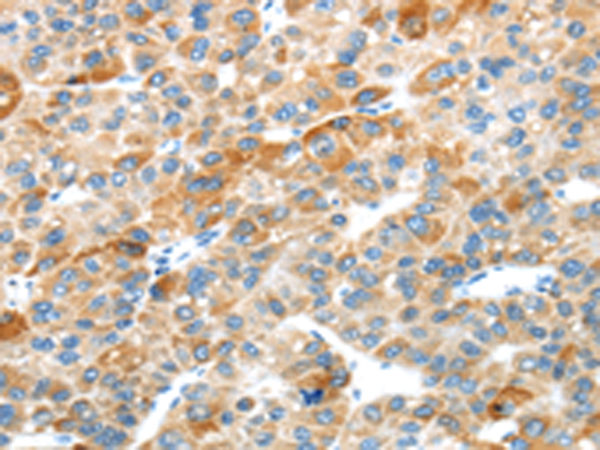

-
分类: 科研抗体货号: P12035别名: DPDE3; PDE43; STRK1; ACRDYS2; HSPDE4D; PDE4DN2应用: WB,IHC反应种属: Human
-
分类: 科研抗体货号: P12051别名: GSD9C应用: WB,IHC反应种属: Human
-
分类: 科研抗体货号: P12033别名: AIP1; ALIX; HP95; DRIP4应用: WB反应种属: Human, Mouse, Rat
-
分类: 科研抗体货号: P12050别名: PHKG应用: WB,IHC反应种属: Human, Mouse, Rat
-
分类: 科研抗体货号: P12067别名:应用: WB,IHC反应种属: Human, Rat
-
分类: 科研抗体货号: P12049别名: PHK; PYK; XLG; PYKL; XLG2; GSD9A应用: IHC反应种属: Human
-
分类: 科研抗体货号: P12066别名: PLEXD1应用: WB,IHC反应种属: Human, Mouse
-
分类: 科研抗体货号: P12048别名: PHKA应用: WB,IHC反应种属: Human, Rat
-
分类: 科研抗体货号: P12065别名: MM1; PLEXB2; Nbla00445; dJ402G11.3应用: IHC反应种属: Human, Mouse
-
分类: 科研抗体货号: P12047别名: PGRP; TAG7; PGRPS; PGLYRP; PGRP-S; TNFSF3L应用: IHC反应种属: Human, Mouse, Rat

鄂公网安备42018502007531号
鄂公网安备42018502007531号

